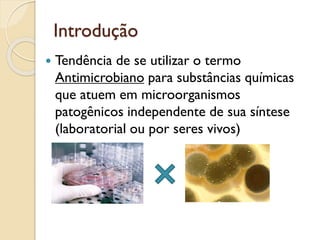
Introdução
 Tendência de se utilizar o termo
Antimicrobiano para substâncias químicas
que atuem em microorganismos
patogênicos independente de sua síntese
(laboratorial ou por seres vivos)

O documento discute vários tipos de antimicrobianos, incluindo sua definição, classificação, mecanismos de ação e usos. É explicado que os antimicrobianos podem ser classificados de acordo com sua estrutura química, mecanismo de ação e espectro de ação. Vários antimicrobianos específicos são detalhados, como sulfas, quinolonas, nitrofurânicos e metronidazol.

![Atividade dos antimicrobianos
Antimicrobianos
Concentração-dependente X Tempo-
dependentes
Concentração-dependente,
◦ quanto ↑ a [ ] sérica acima da CIM, ↑ a taxa de
erradicação ( aminoglicosídeos)
Tempo-dependentes
◦ Fator que mais influencia na eficácia o tempo
que a [ ] plasmática fica acima da CIM
◦ Administração frequente (betalactâmicos)](https://image.slidesharecdn.com/antibioticoscompleto-220906181510-bea20266/85/Antibioticos-completo-pdf-10-320.jpg)



![Antimicrobiano ideal
Destruir os organismos
Amplo espectro de ação
Exercer atividade em fluidos (pus)
Não perturbar as defesas do organismo
Não produzir alergias
Não favorecer resistência
Redistribuir-se em [ ] adequadas
Administração por diferentes vias
Preço acessível](https://image.slidesharecdn.com/antibioticoscompleto-220906181510-bea20266/85/Antibioticos-completo-pdf-14-320.jpg)



![Antimicrobianos em período de
carência
Animais de produção atenção especial
Resíduos de Atb em produtos de origem
animal promovendo danos a saúde humana
Período de carência – Tempo necessário
para que o resíduo de preocupação
toxicológica atinja [ ] seguras](https://image.slidesharecdn.com/antibioticoscompleto-220906181510-bea20266/85/Antibioticos-completo-pdf-18-320.jpg)

![Sulfas, quinolonas e outros
quimioterápicos
Sulfas - Mecanismo de ação
Bacteriostáticas em [ ] terapêuticas
◦ em [ ] altas são bactericida (reações adversas)
Estrutura análoga do ácido PABA,
◦ Substância importante para a formação do DNA
e RNA bacteriano
Efeito antimetabólito – (inibem a formação
de DNA e RNA bacteriano)](https://image.slidesharecdn.com/antibioticoscompleto-220906181510-bea20266/85/Antibioticos-completo-pdf-20-320.jpg)




























![Betalactâmicos
São antibióticos tempo dependentes
◦ Tempo que a [ ] plasmática fica ↑ da CIM
◦ Respeitar intervalo corretamente
Resistência aos betalactâmicos
◦ Betalactamases,
◦ Redução da penetração através da camada externa
da parede celular
◦ Dificuldade do betalactâmico em atingir a proteína](https://image.slidesharecdn.com/antibioticoscompleto-220906181510-bea20266/85/Antibioticos-completo-pdf-49-320.jpg)



























































































![Antibióticos que interferem na
síntese proteica (bacteriostáticos)
Tetraciclinas – Resistência
Efluxo de tetraciclinas, reduzindo sua [ ]
dentro do microorganismo
Proteção dos ribossomos, aonde as
tetraciclinas não se ligam aos ribossomos
Mais comum entre bactérias e mycoplasma
Rara para patógenos intracelulares como
chlamydia, ehrlichia e anaplasma](https://image.slidesharecdn.com/antibioticoscompleto-220906181510-bea20266/85/Antibioticos-completo-pdf-141-320.jpg)









